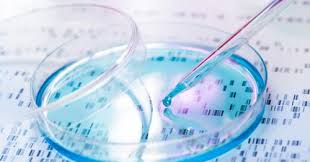

CHICAGO — According to the new market research report “Cell Isolation/Cell Separation Market” published by MarketsandMarkets, the global Cell Isolation Market size is projected to reach $15.0 billion by 2025 from $6.9 billion in 2020.
The increasing government funding for cell-based research, the increasing number of patients suffering from cancer and infectious diseases, technological advancements, and the growing focus on personalized medicine are the major factors driving the cell isolation markets growth. Emerging economies such as China and Japan are providing lucrative opportunities for the players operating in the market, according to the report.
Based on product, the Cell Separation Market is segmented into consumables and instruments. In 2019, consumables segment accounted for the largest share. This can be attributed to the increasing investments by companies to develop technologically advanced products as well as the repetitive use of consumables.
Based on technique, the Cell Separation Market is segmented into centrifugation-based cell isolation, surface marker-based cell isolation, and filtration-based cell isolation. primarily due to the wide usage of this technique among end users. This technique is used on a large scale by biotech and biopharmaceutical companies as well as on a small scale by clinical research organizations and academia. The cost-effectiveness of this technique is another major reason for the large share of this segment. The growing demand for centrifugation techniques in biotech and biopharmaceutical companies is a major factor that is expected to drive the growth of this market segment in the coming years.
The cell isolation market is segmented into hospitals and diagnostic laboratories, biotechnology and biopharmaceutical companies, research laboratories and institutes, and other end users based on end users. In 2019, the biotechnology and biopharmaceutical companies segment accounted for the largest share. The widespread adoption of advanced instruments in cell-based experiments and cancer research in biotechnology and biopharmaceutical companies, as well as the increasing number of R&D facilities globally can be attributed for the large share of this end-user segment.
The Cell Separation Market is segmented into four regions, namely, North America, Europe, Asia Pacific and Rest of the world. In 2019, North America accounted for the largest share of the market. The large share of North America can be attributed to technological advancements, growth in the biotechnology and pharmaceutical industries, increasing prevalence of chronic and infectious diseases, and higher investments in cell-based research in the region.
The major players operating in this Cell Separation Market are Thermo Fisher Scientific, Inc. (US), Becton, Dickinson and Company Limited (US), Beckman Coulter Inc. (US).Merck KGaA (Germany), Terumo BCT (Japan), GE Healthcare (US), Bio- Rad Laboratories Inc. (US), Corning Inc. (US), Roche Diagnostics (Switzerland, Alfa Laval (Sweden), Miltenyl Biotech (Germany), pluriSelect Life Science (Germany), STEMCELL Technologies Inc. (Canada), Akadeum Life Sciences, Inc (US), Bio- Techne (US), Bio Legend (US) and Invent Biotechnologies (US).
MarketsandMarkets provides quantified B2B research on 30,000 high growth niche opportunities/threats.